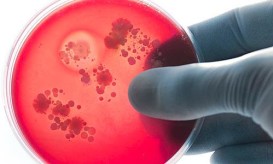

Καμπανάκι από τους ειδικούς: Μην καθυστερείτε τα εμβόλια στα παιδιά
Πολλά και σοβαρή λοιμώδη νοσήματα απειλούν την υγεία των παιδιών και οι γονείς δεν πρέπει να αμελούν τα σωτήρια...

Πολλά και σοβαρή λοιμώδη νοσήματα απειλούν την υγεία των παιδιών και οι γονείς δεν πρέπει να αμελούν τα σωτήρια...

Με τα κρούσματα και τα θύματα της λοίμωξης COVID-19 να αυξάνονται διαρκώς, μοιραία η προσοχή των γονέων στρέφεται περισσότερο...

Η μηνιγγίτιδα Β είναι η πιο συχνή μορφή σοβαρής μηνιγγίτιδας στη χώρα μας. Είναι επομένως επιτακτική η ανάγκη να...

Στον μακρύ κατάλογο περιστατικών μηνιγγίτιδας στη χώρα μας, με την έναρξη της νέας σχολικής χρονιάς έρχεται να προστεθεί ένα...

Με ένα τηλεοπτικό spot, διαθέσιμο εδώ, η GSK εμπλουτίζει την εκστρατεία ενημέρωσης για την Μηνιγγιτιδοκοκκική νόσο Τύπου Β, όπως...

Πριν δυο εβδομάδες το βρέφος μεταφέρθηκε εσπευσμένα στο Ιπποκράτειο Νοσοκομείο Θεσσαλονίκης από την Κομοτηνή και νοσηλεία στο Πανεπιστημιακό Νοσοκομείο...

Το 11ο κρούσμα μηνιγγίτιδας, από την αρχή του έτους, καταγράφηκε στην περιοχή της Κομοτηνής, ενώ πρόκειται για το...

Μετά τα 3 πρόσφατα κρούσματα μηνιγγίτιδας που καταγράφηκαν την προηγούμενη εβδομάδα στα Χανιά, η μαρτυρία μίας μητέρας που κατάγεται...

Η Pfizer Hellas ανακοίνωσε πρόσφατα ότι κυκλοφόρησε στην Ελλάδα το νέο της εμβόλιο TRUMENBA που ενδείκνυται για την ενεργό...

Ένα ακόμη περιστατικό μηνιγγίτιδας προστέθηκε στην λίστα με τα κρούσματα που έχουν παρουσιαστεί στη χώρα μας, στο Χαϊδάρι αυτήν...

Απέναντι σε μια νόσο τόσο ύπουλη και επικίνδυνη όσο η Μηνιγγίτιδα Β, η οποία μεταδίδεται με τις πιο απλές...
Και δεύτερο περιστατικό μηνιγγίτιδας Β έκανε την εμφάνισή του μέσα στον Ιανουάριο με επίσης αίσια έκβαση καθώς το βρέφος...

Μονόδρομο αποτελεί η ενημέρωση του πληθυσμού για την μηνιγγίτιδα τύπου Β και την πρόληψη της μέσω του εμβολιασμού, σύμφωνα...

Σε Νοσοκομείο των Αθηνών μεταφέρθηκε εσπευσμένα το μεσημέρι της Δευτέρας μαθητής του ΕΠΑ.Λ. Χίου από το Πυργί αφού σε...

Σοκ προκάλεσε στους παιδίατρους η είδηση που έχει διαρρεύσει τις τελευταίες ημέρες και μετέδωσε και το iatropedia περί επικείμενης...